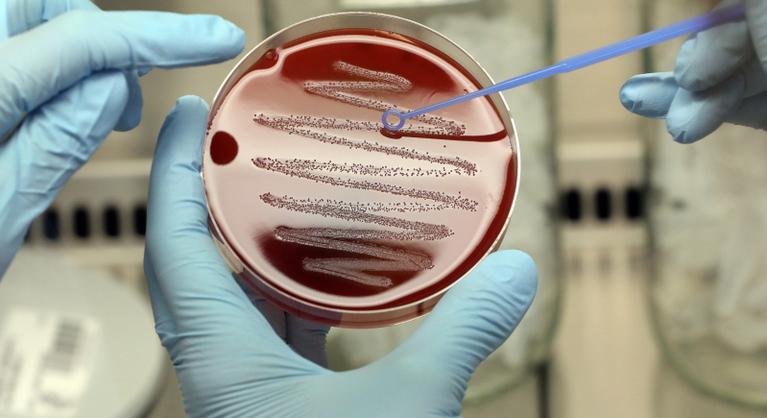
Antibiotikumoknak ellenálló szuperbaktériumok terjednek Ukrajnában: már Európát is fenyegetik

Antibiotikumoknak ellenálló szuperbaktériumok terjednek Ukrajnában: már Európát is fenyegetik
Új antibiotikumok fejlesztésére lenne szükség.

Hamarosan átirányítunk a teljes cikkhez → Index
Új antibiotikumok fejlesztésére lenne szükség.
Hamarosan átirányítunk a teljes cikkhez → Index